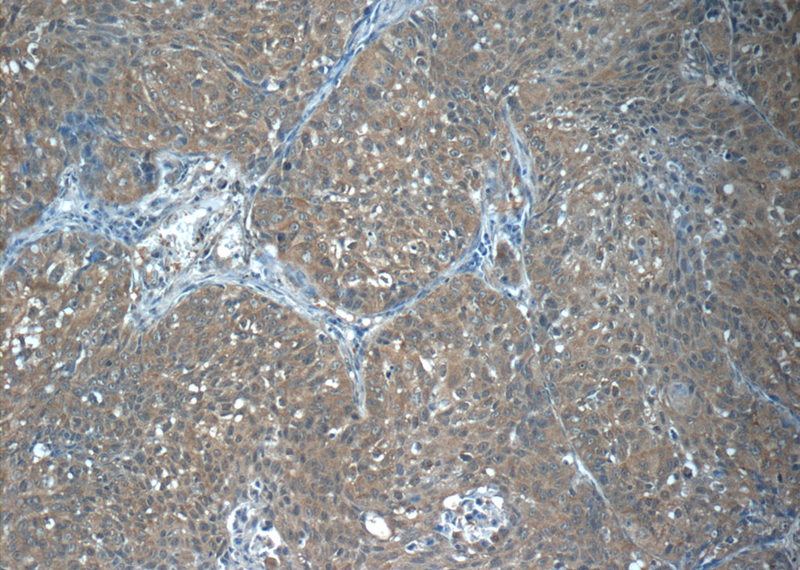
Immunohistochemistry of paraffin-embedded human lung cancer tissue slide using Catalog No:114285(PRX3 Antibody) at dilution of 1:50 (under 10x lens)

-
Product Name
PRX3 antibody
- Documents
-
Description
PRX3 Rabbit Polyclonal antibody. Positive IF detected in HepG2 cells. Positive IHC detected in human lung cancer tissue, human liver cancer tissue. Positive WB detected in HeLa cells. Observed molecular weight by Western-blot: 28 kDa
-
Tested applications
ELISA, WB, IHC, IF
-
Species reactivity
Human,Mouse,Rat; other species not tested.
-
Alternative names
Antioxidant protein 1 antibody; AOP 1 antibody; AOP1 antibody; HBC189 antibody; MER5 antibody; Peroxiredoxin 3 antibody; Peroxiredoxin III antibody; PRDX3 antibody; PRO1748 antibody; Protein MER5 homolog antibody; Prx III antibody; PRX3 antibody; SP 22 antibody
-
Isotype
Rabbit IgG
-
Preparation
This antibody was obtained by immunization of PRX3 recombinant protein (Accession Number: NM_006793). Purification method: Antigen affinity purified.
-
Clonality
Polyclonal
-
Formulation
PBS with 0.1% sodium azide and 50% glycerol pH 7.3.
-
Storage instructions
Store at -20℃. DO NOT ALIQUOT
-
Applications
Recommended Dilution:
WB: 1:200-1:2000
IHC: 1:20-1:200
IF: 1:10-1:100
-
Validations

WB result from Qing-Xi Yue, (PMID:20449493); “Control” and “GAD-treated” above the panel represent the control cells and HeLa cells treated with 10 μMGAD for 48 h, respectively. Each blot is the representative result of three independent experiments.
Immunohistochemistry of paraffin-embedded human lung cancer tissue slide using Catalog No:114285(PRX3 Antibody) at dilution of 1:50 (under 10x lens)

Immunohistochemistry of paraffin-embedded human lung cancer tissue slide using Catalog No:114285(PRX3 Antibody) at dilution of 1:50 (under 40x lens)

Immunofluorescent analysis of HepG2 cells using Catalog No:114285(PRX3 Antibody) at dilution of 1:25 and Alexa Fluor 488-congugated AffiniPure Goat Anti-Rabbit IgG(H+L)
-
Background
PRX3(Peroxiredoxin III) is also named as APO1,PRDX3 and belongs to the AhpC/TSA family.It is involved in redox regulation of the cell and protects radical-sensitive enzymes from oxidative damage by a radical-generating system.PRDX3 is required for MYC-mediated proliferation, transformation, and apoptosis after glucose withdrawal and essential for maintaining mitochondrial mass and membrane potential in transformed rat and human cells(PMID:12011429).
-
References
- Yue QX, Cao ZW, Guan SH. Proteomics characterization of the cytotoxicity mechanism of ganoderic acid D and computer-automated estimation of the possible drug target network. Molecular & cellular proteomics : MCP. 7(5):949-61. 2008.
- Xi L, Zhu SG, Hobbs DC, Kukreja RC. Identification of protein targets underlying dietary nitrate-induced protection against doxorubicin cardiotoxicity. Journal of cellular and molecular medicine. 15(11):2512-24. 2011.
- Chen FQ, Zheng HW, Schacht J, Sha SH. Mitochondrial peroxiredoxin 3 regulates sensory cell survival in the cochlea. PloS one. 8(4):e61999. 2013.
- Prasad R, Chan LF, Hughes CR. Thioredoxin Reductase 2 (TXNRD2) mutation associated with familial glucocorticoid deficiency (FGD). The Journal of clinical endocrinology and metabolism. 99(8):E1556-63. 2014.
- Shiau JY, Yin SY, Chang SL. Mechanistic Study of the Phytocompound, 2- β -D-Glucopyranosyloxy-1-hydroxytrideca-5,7,9,11-tetrayne in Human T-Cell Acute Lymphocytic Leukemia Cells by Using Combined Differential Proteomics and Bioinformatics Approaches. Evidence-based complementary and alternative medicine : eCAM. 2015:475610. 2015.
Related Products / Services
Please note: All products are "FOR RESEARCH USE ONLY AND ARE NOT INTENDED FOR DIAGNOSTIC OR THERAPEUTIC USE"
